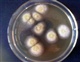
米曲霉

鹤壁市百惠生物科技有限公司
有机肥生产技术,有机肥发酵剂,粪便有机肥,秸秆有机肥,有机肥腐熟剂
关于我们
河南省鹤壁市百惠生物科技有限公司简介 河南省鹤壁市百惠生物科技有限公司是从事微生物制品研究、开发、销售的技术驱动型企业。公司依托国内著名微生物学、菌物学博士及科研实验室,以研究开发农业微生物制品作为核心,主营业务涵盖畜禽粪便、农作物秸秆等废弃物资源化利用、有机肥料生产技术、生物肥料生产技术、绿色生态种植技术、有机生态养殖技术等领域。公司依靠优良的技术开发实力和技术水平,创建了完善的菌种及生物制品研发体系。逐步推进农业微生物菌种及下游相关... >> 查看更多